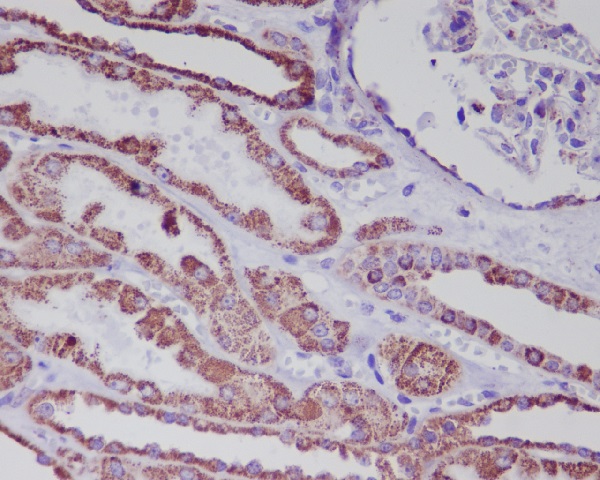

| Western blot (WB): | 1:500-2000 |
| Immunohistochemistry (IHC): | 1:50-200 |

Western blot analysis of Hsp60 expression in (1) HeLa cell lysate; (2) 293T cell lysate; (3) NIH/3T3 cell lysate; (4) Mouse heart lysate; (5) PC-12 cell lysate; (6) Rat heart lysate.

All lanes use the Antibody for 1 hour at room temperature.

All lanes use the Antibody for 1 hour at room temperature.

All lanes use the Antibody for 1 hour at room temperature.

All lanes use the Antibody for 1 hour at room temperature.

Immunohistochemical analysis of paraffin-embedded human kidney, using Hsp60 Antibody .

Western blot analysis of Hsp60 expression in (1) HeLa cell lysate; (2) 293T cell lysate; (3) NIH/3T3 cell lysate; (4) Mouse heart lysate; (5) PC-12 cell lysate; (6) Rat heart lysate.

All lanes use the Antibody for 1 hour at room temperature.

All lanes use the Antibody for 1 hour at room temperature.

All lanes use the Antibody for 1 hour at room temperature.

All lanes use the Antibody for 1 hour at room temperature.

Immunohistochemical analysis of paraffin-embedded human kidney, using Hsp60 Antibody .